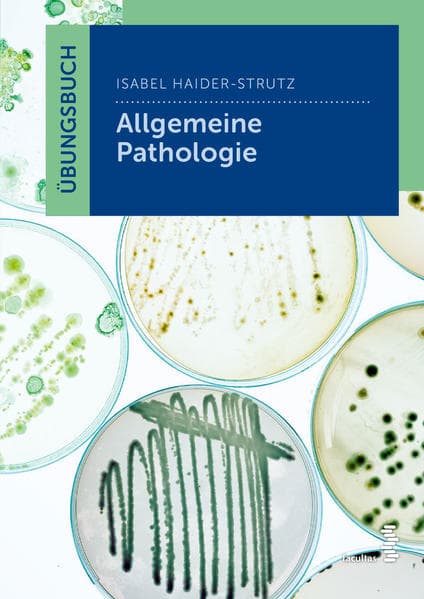
Übungsbuch Allgemeine Pathologie

904 Treffer
Geimpft - gestorben: Histopathologischer Atlas der Corona-Impfschäden
Ute Dr Krüger, Walter Lang, Ute KrügerBuch (gebunden)
Versand in 3 Wochen
39,00 €*
14,95 €*
80 Fälle Innere Medizin: Aus Klinik und Praxis (inkl. 25 Audio-Fällen)
Torben Pottgießer, Stefanie Ophoven, Elisabeth…Buch (kartoniert)
Sofort lieferbar
42,00 €*
Ein weiteres Format
Buch (kartoniert)
Sofort lieferbar
45,60 €*
Buch (kartoniert)
Sofort lieferbar
26,00 €*
Ein weiteres Format
Buch (kartoniert)
Sofort lieferbar
71,00 €*
Ein weiteres Format
Buch (kartoniert)
Sofort lieferbar
54,99 €*
Ein weiteres Format
Histologie - Das Lehrbuch: Zytologie, Histologie und mikroskopische Anatomie
Thomas Deller, Ulrich Welsch, Wolfgang KummerBuch (gebunden)
Sofort lieferbar
54,00 €*
Buch (kartoniert)
Sofort lieferbar
42,00 €*
Ein weiteres Format
Arbeitsbuch Anatomie und Physiologie: für Pflege- und andere Gesundheitsfachberufe
Erica Brühlmann-JecklinBuch (kartoniert)
Sofort lieferbar
39,00 €*
Ein weiteres Format
Buch (kartoniert)
Sofort lieferbar
18,99 €*
Ein weiteres Format
Buch (gebunden)
Sofort lieferbar
265,00 €*
Ein weiteres Format
Buch (kartoniert)
Sofort lieferbar
45,00 €*
Ein weiteres Format
Buch (gebunden)
Sofort lieferbar
34,99 €*
Buch (gebunden)
Sofort lieferbar
29,99 €*
Buch (gebunden)
Sofort lieferbar
104,00 €*
Buch (kartoniert)
Sofort lieferbar
30,00 €*
Buch (gebunden)
Sofort lieferbar
69,00 €*
Ein weiteres Format
Grundwissen Rechtsmedizin: Medizinische Kriminalistik und forensische Wissenschaften mit eLearning-Kurs
Michael BohnertTaschenbuch
Sofort lieferbar
29,90 €*
Ein weiteres Format
Curriculum Spezielle Pathologie für Zahnmediziner: Allgemeine Entzündungslehre, Tumoren und tumorartige Läsionen der Mundschleimhaut, Erkrankungen der Haut mit oralen Manifestationen, Systemische Erkrankungen, Erkrankungen der Speicheldrüsen, Zysten im Kiefer- und Gesichtsbereich, Odontogene Tumoren, E...
Harald Ebhardt, Peter A. Reichart, Andrea Maria…Buch (kartoniert)
Sofort lieferbar
48,00 €*
Ein weiteres Format
Übungsbuch Anatomie, Biologie, Physiologie: für Gesundheitsberufe
Isabel Haider-Strutz, Marianne PatakiBuch (kartoniert)
Sofort lieferbar
22,30 €*
Buch (gebunden)
Sofort lieferbar
38,00 €*
Ein weiteres Format
Buch (kartoniert)
Sofort lieferbar
26,80 €*
Buch (kartoniert)
Sofort lieferbar
27,00 €*
Ein weiteres Format
Buch (kartoniert)
Sofort lieferbar
29,00 €*
Ein weiteres Format
Differenzialdiagnostik in der Manuellen Medizin für die Wirbelsäule: Leitsymptome und Pathologien
Jan NeuerTaschenbuch
Sofort lieferbar
65,00 €*
Ein weiteres Format
Buch (gebunden)
Sofort lieferbar
71,00 €*
Taschenbuch
Sofort lieferbar
67,00 €*
Ein weiteres Format
Die Heilpraktiker-Akademie. Basiswissen: Terminologie, Chemie/Biochemie, Zytologie/Histologie, Allgemeine Pathologie
Rudolf SchweitzerTaschenbuch
Sofort lieferbar
31,00 €*
Ein weiteres Format
Taschenbuch
Sofort lieferbar
33,00 €*
Differenzialdiagnostik in der Manuellen Medizin für die Extremitäten: Leitsymptome und Pathologien
Jan NeuerBuch (kartoniert)
Sofort lieferbar
65,00 €*
Ein weiteres Format
Osborn's Brain: Bildgebung, Pathologie und Anatomie
Anne G. Osborn, Garry L. Hedlund, Karen L. SalzmanBuch (gebunden)
Sofort lieferbar
259,00 €*
Taschenbuch
Sofort lieferbar
31,00 €*
Ein weiteres Format
Taschenbuch
Sofort lieferbar
27,00 €*
Taschenbuch
Sofort lieferbar
50,00 €*
Ein weiteres Format
Farbatlas und Lehrbuch der Mundschleimhauterkrankungen: Mundschleimhaut - Lippen - Mundumgebung
Manfred Straßburg, Gerdt KnolleBuch (gebunden)
Sofort lieferbar
137,99 €*
Handbuch für Bluthochdruck, Herz-und Arteriosklerosekranke: Diätanleitungen zur Verhütung und Heilung mit Rezeptteil, eingehende Ratschläge und ausgearbeiteter Kurplan aus einem ärztlichen Zentrum modernster Heilkunst
Pascal Bircher, Andres Bircher, Lilli Bircher,…Buch (gebunden)
Sofort lieferbar
49,80 €*
Buch (kartoniert)
Sofort lieferbar
74,99 €*
Ein weiteres Format
Buch (kartoniert)
Sofort lieferbar
48,00 €*
Buch (kartoniert)
Sofort lieferbar
14,50 €*
Ein weiteres Format
Buch (gebunden)
Sofort lieferbar
71,00 €*
Die besten Akupunkturindikationen Kopfschmerzen und weitere Erkrankungen der Kopfregion: Eine Arbeitsanleitung in Wort und Bild
Michael RupprechtTaschenbuch
Sofort lieferbar
24,95 €*
Ein weiteres Format
Taschenbuch
Sofort lieferbar
51,00 €*
Ein weiteres Format
Buch (gebunden)
Sofort lieferbar
24,80 €*
Ein weiteres Format
Buch (gebunden)
Sofort lieferbar
144,00 €*
Mitbetroffen von Aphasie: Persönliche Situation, Lebensqualität und psychosoziale Selbsthilfe-Unterstützungsgruppen für Angehörige
Sabrina ZiehrBuch (kartoniert)
Sofort lieferbar
58,00 €*
Buch (kartoniert)
Sofort lieferbar
28,90 €*
Ein weiteres Format
Fallbasierte Unterrichtsgestaltung - Grundlagen und Konzepte: Didaktischer Leitfaden für Lehrende
Juliane Dieterich, Karin ReiberBuch (kartoniert)
Sofort lieferbar
24,99 €*
Ein weiteres Format
Buch (kartoniert)
Sofort lieferbar
54,99 €*
Taschenbuch
Sofort lieferbar
26,90 €*
Ein weiteres Format
Noch einmal schwimmen: Sterbebegleitung meiner krebskranken Mutter. Erfahrungsbericht und Ratgeber
Monika KeckBuch (kartoniert)
Sofort lieferbar
16,90 €*
Ein weiteres Format
Buch (kartoniert)
Sofort lieferbar
16,40 €*
Gelenkpathologie: Historische Grundlagen, Ursachen und Entwicklungen von Gelenkleiden und ihre Pathomorphologie
Winfried MohrBuch (kartoniert)
Sofort lieferbar
119,99 €*
60 von 904